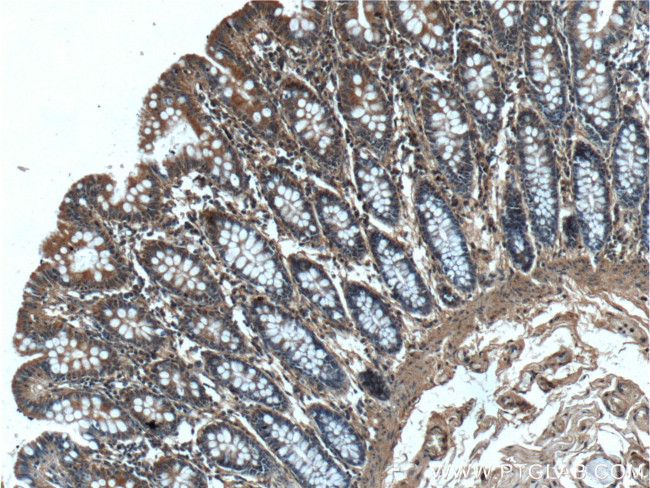
NARFL Antibody in Immunohistochemistry (Paraffin) (IHC (P))

Search
Proteintech
NARFL Polyclonal Antibody
{{$productOrderCtrl.translations['antibody.pdp.commerceCard.promotion.promotions']}}
{{$productOrderCtrl.translations['antibody.pdp.commerceCard.promotion.viewpromo']}}
{{$productOrderCtrl.translations['antibody.pdp.commerceCard.promotion.promocode']}}: {{promo.promoCode}} {{promo.promoTitle}} {{promo.promoDescription}}. {{$productOrderCtrl.translations['antibody.pdp.commerceCard.promotion.learnmore']}}
产品信息
13652-1-AP
种属反应
宿主/亚型
分类
类型
抗原
偶联物
形式
浓度
规格
纯化类型
保存液
内含物
保存条件
运输条件
产品详细信息
Immunogen sequence: QLNPTDTAR KLTSFFKKIG VHFVFDTAFS RHFSLLESQR EFVRRFRGQA DCRQALPLLA SACPGWICYA EKTHGSFILP HISTARSPQQ VMGSLVKDFF AQQQHLTPDK IYHVTVMPCY DKKLEASRPD FFNQEHQTRD VDCVLTTGEV FRLLEEEGVS LPDLEPAPLD SLCSGASAEE PTSHRGGGSG GYLEHVFRHA ARELFGIHVA EVTYKPLRNK DFQEVTLEKE GQVLLHFAMA YGFRNIQNLV QRLKRGRCPY HYVEVMACPS GCLNGGGQLQ APDRPSRELL QHVERLYGMV RAEAPEDAPG VQELYTHWLQ GTDSECAGRL LHTQYHAVEK ASTGLGIRW (129-476 aa encoded by BC030248)
靶标信息
Component of the cytosolic iron-sulfur protein assembly (CIA) complex, a multiprotein complex that mediates the incorporation of iron-sulfur cluster into extramitochondrial Fe/S proteins. Seems to negatively regulate the level of HIF1A expression, although this effect could be indirect.
仅用于科研。不用于诊断过程。未经明确授权不得转售。
篇参考文献 (0)
生物信息学
蛋白别名: Cytosolic Fe-S cluster assembly factor NARFL; Cytosolic iron-sulfur assembly component 3; HPRN; IOP1; Iron-only hydrogenase-like protein 1; LET1 like/JFP15; nuclear prelamin A recognition factor like; Nuclear prelamin A recognition factor-like protein; Protein related to Narf; unnamed protein product
基因别名: 9030612I22Rik; AI504405; CIAO3; HPRN; IOP1; LET1L; NAR1; NARFL; PRN
UniProt ID: (Human) Q9H6Q4, (Mouse) Q7TMW6, (Rat) Q5BK18
Entrez Gene ID: (Human) 64428, (Mouse) 67563, (Rat) 360496